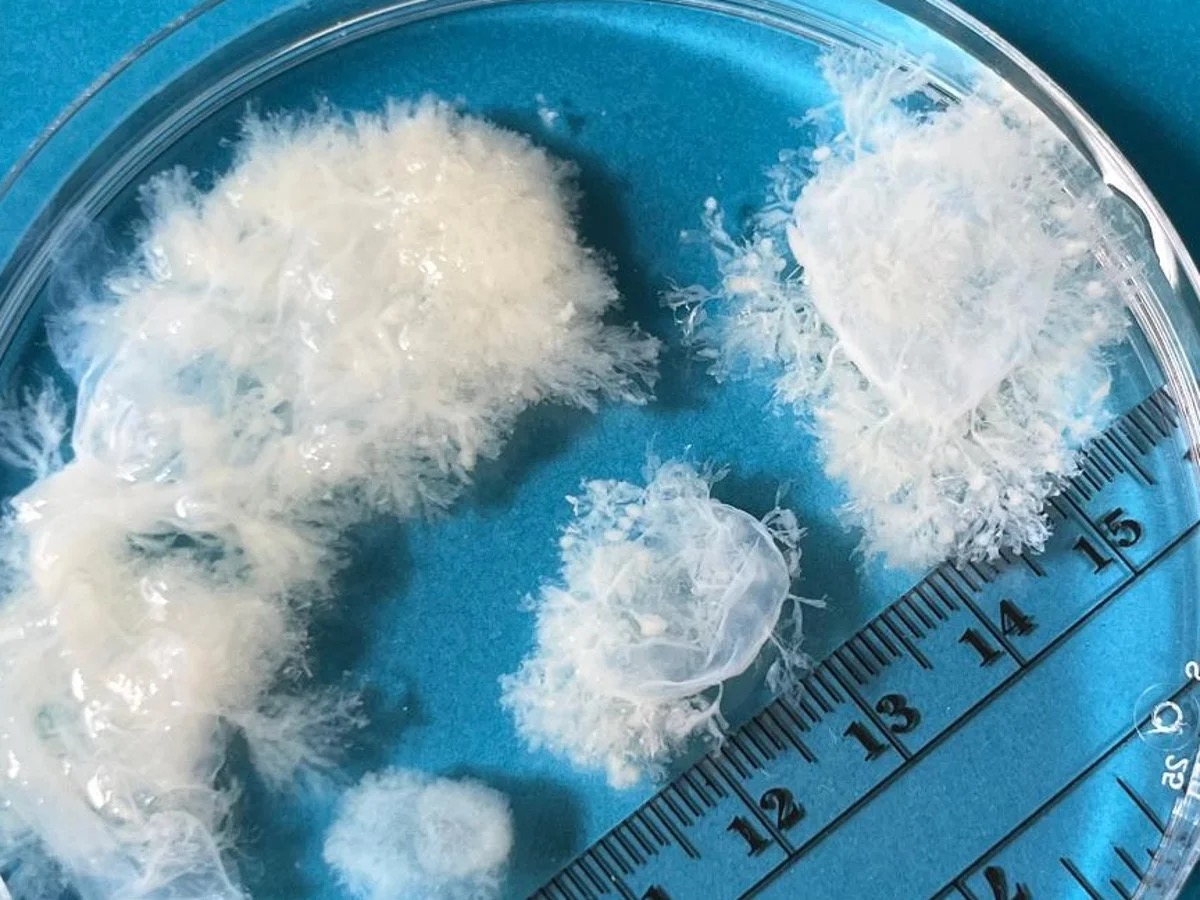
~M~ tweet media

@Yes784360650955 @revisionistah @CantBeSilenced8 I meant human as in a 'person'. the generalized species of a fetus would fall under the umbrella of a human mammal
English
~M~
141 posts


@_ItsLiterallyM_
uhhh secret alt woahhh //moribund ano🦖ia recovery||Latina Canadian||A-EMS since 16!!||pre med BSMD accepteé||future gen surg 😎||ao3 addict who??// fuck MAGA